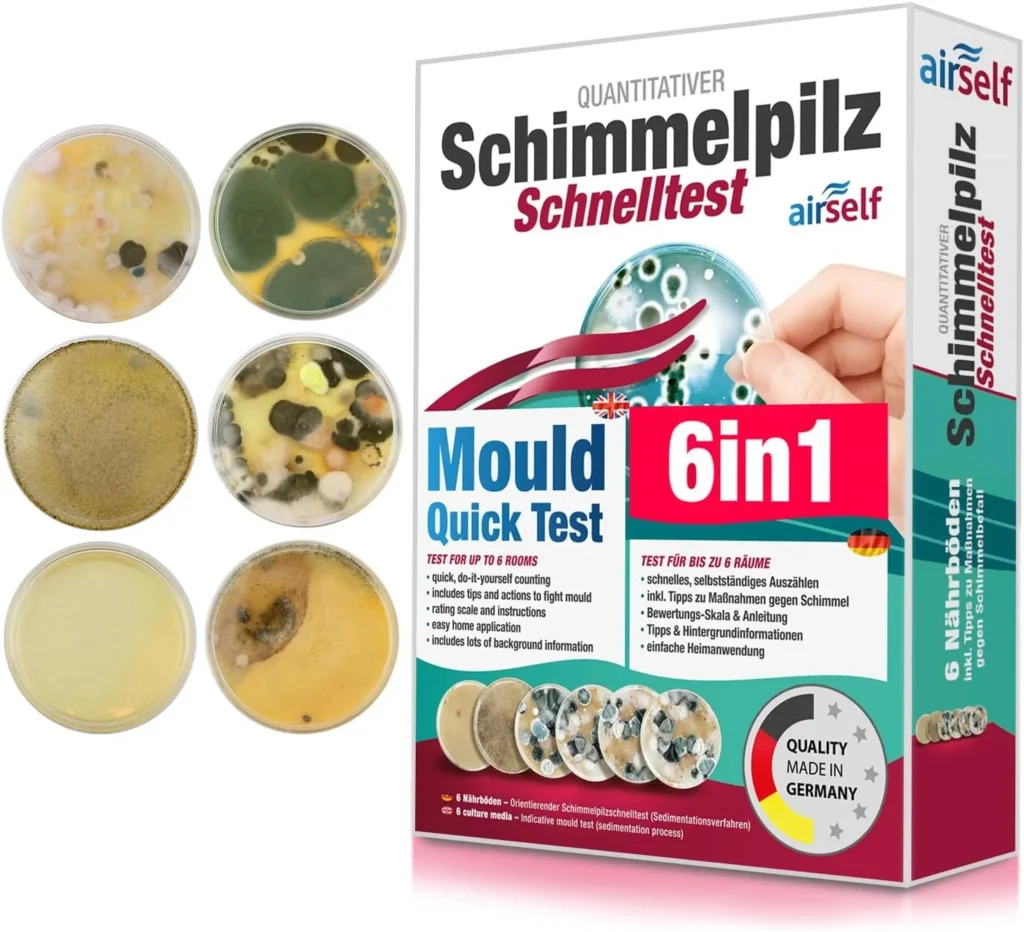
airself mould rapid test airself mould rapid test

Test result preview
Product description of the manufacturer
The height-adjustable desk from Wonavo is a modern and ergonomic solution for working in the home office or office. Thanks to the robust steel frame in industrial quality, the model is extremely stable and durable. The MDF table top is not only aesthetically pleasing, but also easy to clean. As it consists of a single piece , it has a clear advantage over multi-piece tops. The table can be electrically height-adjusted from 70 to 120 cm . With its intelligent control panel, which has four memory functions and an LED display, the product enables a quick change between sitting and standing positions. The product can be set up within 10 to 15 minutes. It is ideal for anyone who values healthy working, flexibility and sophisticated technology.
Advantages
- Robust steel construction
- Quiet, stepless height adjustment
- Easy to operate
Disadvantages
- Table top heavy and unwieldy during assembly
- Minor damage during transport
The first impression
Packaging and contents
Here we take a closer look at the packaging. Sustainability is becoming an increasingly important factor. In addition, adequate protection of the product must of course also be guaranteed. Are the contents of the packaging complete and does the manufacturer make it as easy as possible for me to use the product straight away?
Here we take a closer look at the packaging. Sustainability is becoming an increasingly important factor. In addition, adequate protection of the product must of course also be guaranteed. Are the contents of the packaging complete and does the manufacturer make it as easy as possible for me to use the product straight away?
show more +Criterion
Comment
Score achieved*
Product protection
Carton is not 100% stable, product partly slightly damaged
Points
Sustainability Packaging
No unnecessary packaging waste, the plastic surround protects the product components
Points
Package contents & scope
Complete, including assembly tool
Points
Instructions for use
Illustrated and clearly written in German, assembly video via scan
points
TOTAL
93
points
Weighting: 20%
*Themaximum score is 100 points
The height-adjustable desk from Wonavo is very well packaged to provide optimum protection during transport. Unfortunately, the goods were not handled with the necessary care by the haulier, so that parts of the goods were damaged even though the protection was actually perfectly adequate. Despite the avoidance of unnecessary packaging waste, the use of plastic could be seen as critical by some consumers. The product packaging contains the individual components of the height-adjustable frame, a table top and the electronics. An illustrated instruction manual in German is also included. An assembly video can also be scanned if required.

The first time in the hand
Product finish and appearance
Before we start the practical test, we take a close look at the workmanship of the products. How high quality are the materials used? Are the look and feel satisfactory?
Before we start the practical test, we take a close look at the workmanship of the products. How high quality are the materials used? Are the look and feel satisfactory?
show more +Criterion
Comment
Score achieved*
Visual appearance
Good design
points
Workmanship
Good workmanship
points
Stability
Very stable
points
Sustainability of the product
No information
points
TOTAL
83
points
Weighting: 20%
*Themaximum score is 100 points

The height-adjustable desk from Wonavo impresses with its good design and high-quality materials. Thanks to its simple yet stylish exterior, it adds a modern touch to the room. The material used looks stable and robust. Unfortunately, there are marks on the corners of the table. These could possibly have been caused by transport. The legs and swings are very stable, but the powder coating is not 100 per cent clean and there are scratches. However, these are only noticeable on closer inspection and could also have been damaged during transport. Nevertheless, the stable quality and the powder coating indicate a certain durability . This speaks in favour of the product’s sustainability .
This is what our practical test revealed
Does the manufacturer keep its advertising promises?
Our practical test has the highest relevance and therefore weighting. Here, the product has to undergo a wide range of criteria and tests. We check the functions and product promises of the test article.
Our practical test has the highest relevance and therefore weighting. Here, the product has to undergo a wide range of criteria and tests. We check the functions and product promises of the test article.
show more +Criterion
Comment
Score achieved*
Height adjustment
Rapid up and down movement even under load, smooth starting and stopping, height adjustment between 70-120 cm, stepless, quiet
points
Controls
Easy to operate, practical memory buttons, safety stop, LED height indicator
points
Surface finish
Easy cleaning possible, damage to corners
points
Installation
Quick and easy, assembly tool included, but extreme caution is required when setting up
points
Ergonomics
Ergonomic working, for well-being and efficiency
points
OVERALL
88
points
Weighting: 45%
*Themaximum score is 100 points
We tested the electrically height-adjustable desk from Wonavo intensively as part of our practical test. We were completely convinced by the height adjustment : it runs smoothly, smoothly and quietly and can also handle higher loads without any restrictions. The stepless adjustment between 70 and 120 cm is carried out via an intuitive control panel with practical memory buttons, LED display and child safety lock. All functions were fully usable in our tests, regardless of weight or set height.
The tabletop surface has a high-quality finish and is easy to clean. Transport damage to the corners did not impair functionality. The maximum load capacity was reached in the centre area, but point loads at the edges should be avoided.
Assembly was straightforward thanks to the well-structured instructions and the tools supplied. However, due to the heavy weight, it is best to have at least two people to set it up. Care should be taken when setting up, as incorrect handling can result in damage to pre-assembled components.
In daily use, the desk proved its well thought-out, ergonomic design, which comfortably supports both sitting and standing positions. All testers reported an increased sense of well-being and more efficient work processes – in keeping with the concept of an ergonomic workplace.
The height-adjustable desk from Wonavo fulfils all the manufacturer’s specifications with flying colours and is a clear recommendation for healthy and flexible working in the office or at home.

Test plan
You can find a detailed insight into the evaluation criteria of the practical part of the test and the points distribution here. If you are also interested in the evaluation of our other test criteria, please read our document on the evaluation process.
Price/performance ratio
and consumer reviews
Finally, we analyse how the product compares to the competition. Can it keep up with the competition in terms of price and quality? Would we generally recommend buying it?
Finally, we analyse how the product compares to the competition. Can it keep up with the competition in terms of price and quality? Would we generally recommend it for purchase?
show more +Criterion
Comment
Score achieved*
Price / performance ratio
Good performance in the upper price segment
points
TOTAL
60
points
Weighting: 15%
*Themaximum score is 100 points
Prices of up to €429.00 are charged on the Internet for equivalent products. Very affordable products are available from as little as € 199.00 . The height-adjustable desk from Wonavo is therefore currently in the upper price segment with a price of € 399.00. For the quality and performance received, the price-performance ratio is good.
Overall result
Weighting
Score achieved*
1. packaging & content
20%
points
2. product processing & appearance
20%
points
3. in the practical test
45%
points
4. price/performance rating
15%
points
TOTAL
points
*Themaximum score is 100 points